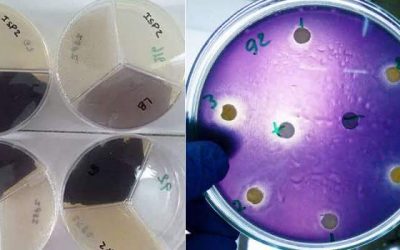
Bacterias marinas se podrían aprovechar como bioplaguicidas

La yerba mate crece en el mercado interno y externo
La Secretaría de Agroindustria nacional destacó que entre enero y agosto la yerba mate con destino al mercado interno marcó el segundo mejor registro de los últimos cinco años y las exportaciones crecieron un 33,7 %, respecto a los primeros ocho meses de 2017.
Nutrición: Un alga invasora y molesta, de las costas patagónicas al plato
La undaria pinnatifida llegó hace 20 años en un barco coreano. Rechazada por pescadores, buzos y turistas, promueven su consumo por su gran aporte nutritivo.
Rusia y China denuncian las nuevas sanciones estadounidenses
Por Thibaut MARCHAND con Ludovic EHRET en Pekín .
Rusia y China mostraron su indignación este viernes ante las nuevas sanciones anunciadas por Washington contra los dos países, atizando la tensión en un contexto de guerra comercial.
Se presentó en Cafayate, Salta, el proyecto de creación de la Ruta del Vino Casero y Artesanal
Este proyecto busca estructurar una ruta turística basada en la elaboración de vinos artesanales de los Valles Calchaquíes de la Provincia de Salta.
Los fabricantes de champán hacen burbujas sobre una cosecha extraordinaria causada por la sequía en Europa
En esta época del año, estas viñas están cargadas de racimos de uvas moradas oscuras – pinot noir y pinot meunier – así como de uvas chardonnay de color verde claro, las tres variedades se mezclan para hacer champán.
Comenzó la inscripción en el RENSPA a frutihorticultores de la Patagonia
El Servicio Nacional de Sanidad y Calidad Agroalimentaria (Senasa) informó a los productores frutícolas y hortícolas de la Patagonia que está abierta la inscripción y reinscripción en el Registro Nacional Sanitario de Productores Agropecuarios (Renspa)y en los Programas de Exportación de Frutas Frescas hacia Brasil, México, Israel y China.
Impulsan el cultivo de moringa en el norte del país
Por sus cualidades nutritivas y el potencial antibacterial, fúngico y homeostático de sus hojas, vainas y semillas, esta planta representa una alternativa para agricultores de Salta y Formosa. Técnicos del INTA brindan recomendaciones para la producción.
Macri visitó campos de arándanos en Tucumán y se comprometió a reducir alícuotas de exportación
El presidente Mauricio Macri visitó el campo «El Molino», en el departamento tucumano de Chicligasta, donde se producen y empacan distintas variedades de arándanos frescos y congelados para su exportación a Estados Unidos, Canadá, China y varios países de Europa
Tesãí, el té antioxidante a base de hierbas ancestrales
Investigadores del INTA y la Universidad del Litoral –Santa Fe– desarrollaron una infusión instantánea natural sin aditivos químicos sintéticos y con propiedades benéficas que ayudan a prevenir el envejecimiento y daño celular
Festival de Arte argentino llega a la ciudad de Kuala Lumpur
«Argentina Festival de Arte» (ARFA2018) llegará en octubre a la ciudad de Kuala Lumpur en Malasia.
Modernización tecnológica para productores de Mendoza y San Juan
Programa «De productor a empresario», busca aumentar la eficiencia del trabajo de poda en un 30 o 40 por ciento y a la vez mejorar las condiciones de los trabajadores de viña.
Bacterias marinas se podrían aprovechar como bioplaguicidas
Ciencia & Tecnología
Innovación tecnológica: comederos inteligentes evalúan la conducta de las vacas
El sistema fue desarrollado por investigadores del INTA Anguil –La Pampa– y recibió el galardón de oro que entrega el Centro Internacional de Innovación en Tecnología Agropecuaria (CiTA).
Las cerezas frescas ya pueden obtener el sello de calidad Alimentos Argentinos
Las empresas productoras de cerezas interesadas en distinguir sus frutos con el sello "Alimentos Argentinos una Elección Natural", y su versión en idioma inglés "Argentine Food a Natural Choice", tienen ahora la posibilidad de obtenerlo